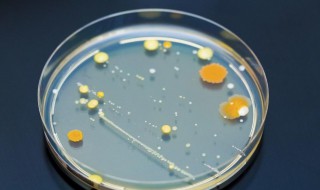
真菌培养方法四个步骤 真菌培养方法四个步骤是什么

1、配置营养基:选择牛肉汁等营养物质与琼脂混合在一起配置成营养基。
2、高温灭菌:将配置好的营养基进行高温灭菌,目的是杀死培养基中原有的细菌和真菌及他们的孢子。
3、冷却接种:将少量的的细菌或真菌转移到培养基上的过程。接种时应在无菌环境下进行,并且做好环境与器械的消毒灭菌工作,防止杂菌感染。培养基冷却后方可接种,以防止高温而杀死细菌或者真菌。
4、恒温培养:将接种后的培养皿放在恒温箱中进行培养。
生活常识2022-10-08 05:38:19佚名
1、配置营养基:选择牛肉汁等营养物质与琼脂混合在一起配置成营养基。
2、高温灭菌:将配置好的营养基进行高温灭菌,目的是杀死培养基中原有的细菌和真菌及他们的孢子。
3、冷却接种:将少量的的细菌或真菌转移到培养基上的过程。接种时应在无菌环境下进行,并且做好环境与器械的消毒灭菌工作,防止杂菌感染。培养基冷却后方可接种,以防止高温而杀死细菌或者真菌。
4、恒温培养:将接种后的培养皿放在恒温箱中进行培养。
小虾皮制作方法 小虾皮怎么做